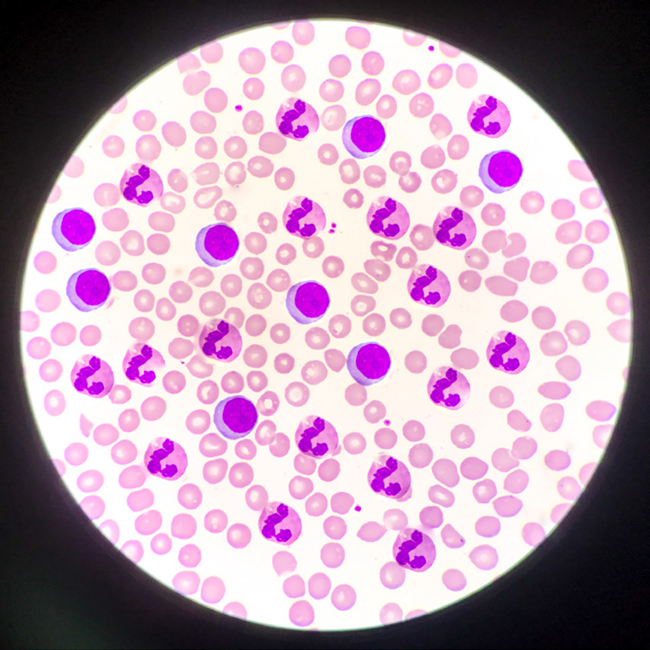
What are the sources of red blood cell contamination?

The cell therapy field has undergone rapid expansion in the last decade, driven by numerous accomplishments in chimeric antigen receptor (CAR) T-cell therapies for lymphomas and leukemias.
The research and development of these life-saving treatments begins with starting material obtained from a healthy donor: a source for peripheral blood mononuclear cells (PBMCs).
Starting material cell populations can be homogenous—like isolated immune cell subsets or apheresis products—or heterogenous—such as leukocyte reduction system (LRS) cones, whole blood, or plasma-suspended buffy coats.
Heterogenous cell populations pose the risk of red blood cell (RBC) contamination, which can adversely impact downstream cell cultures.
While the initial cost of this heterogeneous starting material is typically lower than its purified counterparts, are these upfront savings maintained throughout the research and development process?
Sources of contamination
RBC contamination can arise from various sources. For example, manual isolation of the PBMC layer from whole blood employing density gradient media necessitates a deft operator, completely trained with established standard operating procedures (SOPs). However, differences in the patient initial material may still produce a thin PBMC layer, potentially elevating the risk of contamination.
Image Credit: BioIVT, LLC
Even partially fractionated sources of PBMCs, like LRS cones, have demonstrated significant RBC contamination (often as many as 6x1010 RBCs per cone).
Further methods, such as RBC lysis buffers and washing steps, can minimize the risk of contamination from heterogeneous starting materials. However, these techniques add to the total labor and reagent costs.
About BioIVT
BioIVT, formerly BioreclamationIVT, is a leading global provider of high-quality biological specimens and value-added services. We specialize in control and disease state samples including human and animal tissues, cell products, blood, and other biofluids. Our unmatched portfolio of clinical specimens directly supports precision medicine research and the effort to improve patient outcomes by coupling comprehensive clinical data with donor samples.
Our Research Services team works collaboratively with clients to provide in vitro hepatic modeling solutions. And as the world’s premier supplier of ADME-Tox model systems, including hepatocytes and subcellular fractions, BioIVT enables scientists to better understand the pharmacokinetics and drug metabolism of newly discovered compounds and the effects on disease processes. By combining our technical expertise, exceptional customer service, and unparalleled access to biological specimens, BioIVT serves the research community as a trusted partner in ELEVATING SCIENCE®.
Sponsored Content Policy: News-Medical.net publishes articles and related content that may be derived from sources where we have existing commercial relationships, provided such content adds value to the core editorial ethos of News-Medical.Net which is to educate and inform site visitors interested in medical research, science, medical devices and treatments.